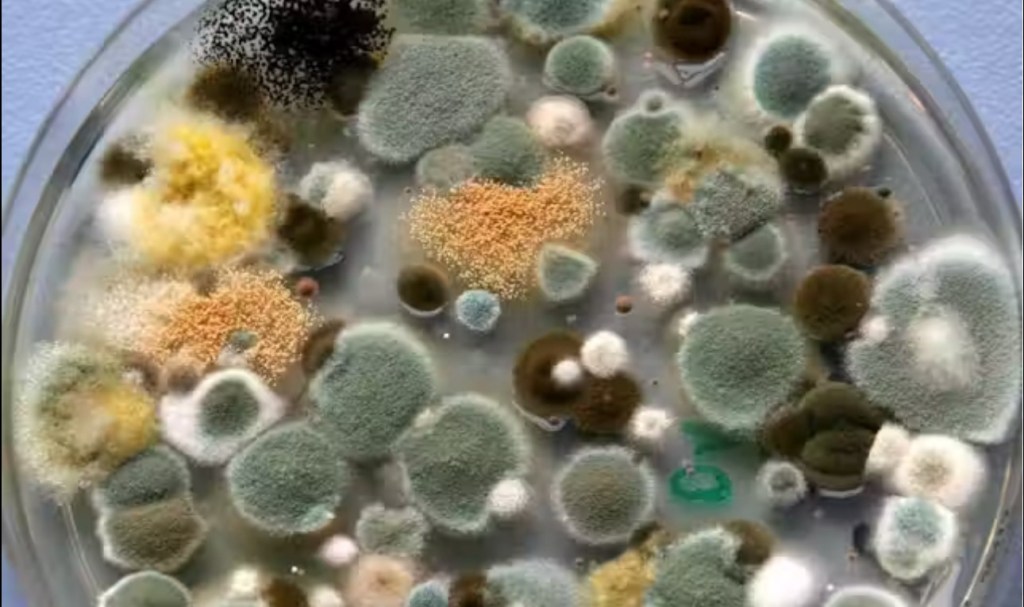

El moho es una amenaza silenciosa en hogares y oficinas, comprometiendo tanto la salud como la estructura de los inmuebles. En México, la humedad relativa en ciertas regiones favorece su proliferación.
Especialistas en la calidad del aire informaron que el moho afecta los últimos cinco años la salud en las personas principalmente en las enfermedades respiratorias que han aumentado un 25 por ciento.
Según la Organización Mundial de la Salud (OMS), la exposición al moho puede provocar alergias, problemas respiratorios e incluso infecciones pulmonares graves como la aspergilosis.
Advirtieron que la falta de ventilación en espacios cerrados agrava el problema.
Casos recientes en la Ciudad de México han demostrado cómo la acumulación de humedad en oficinas sin ventilación adecuada ha provocado fatiga crónica y problemas respiratorios en empleados.
Entre las soluciones recomendadas están el uso de extractores inteligentes, ventilación cruzada y la inspección periódica de ductos de aire acondicionado.